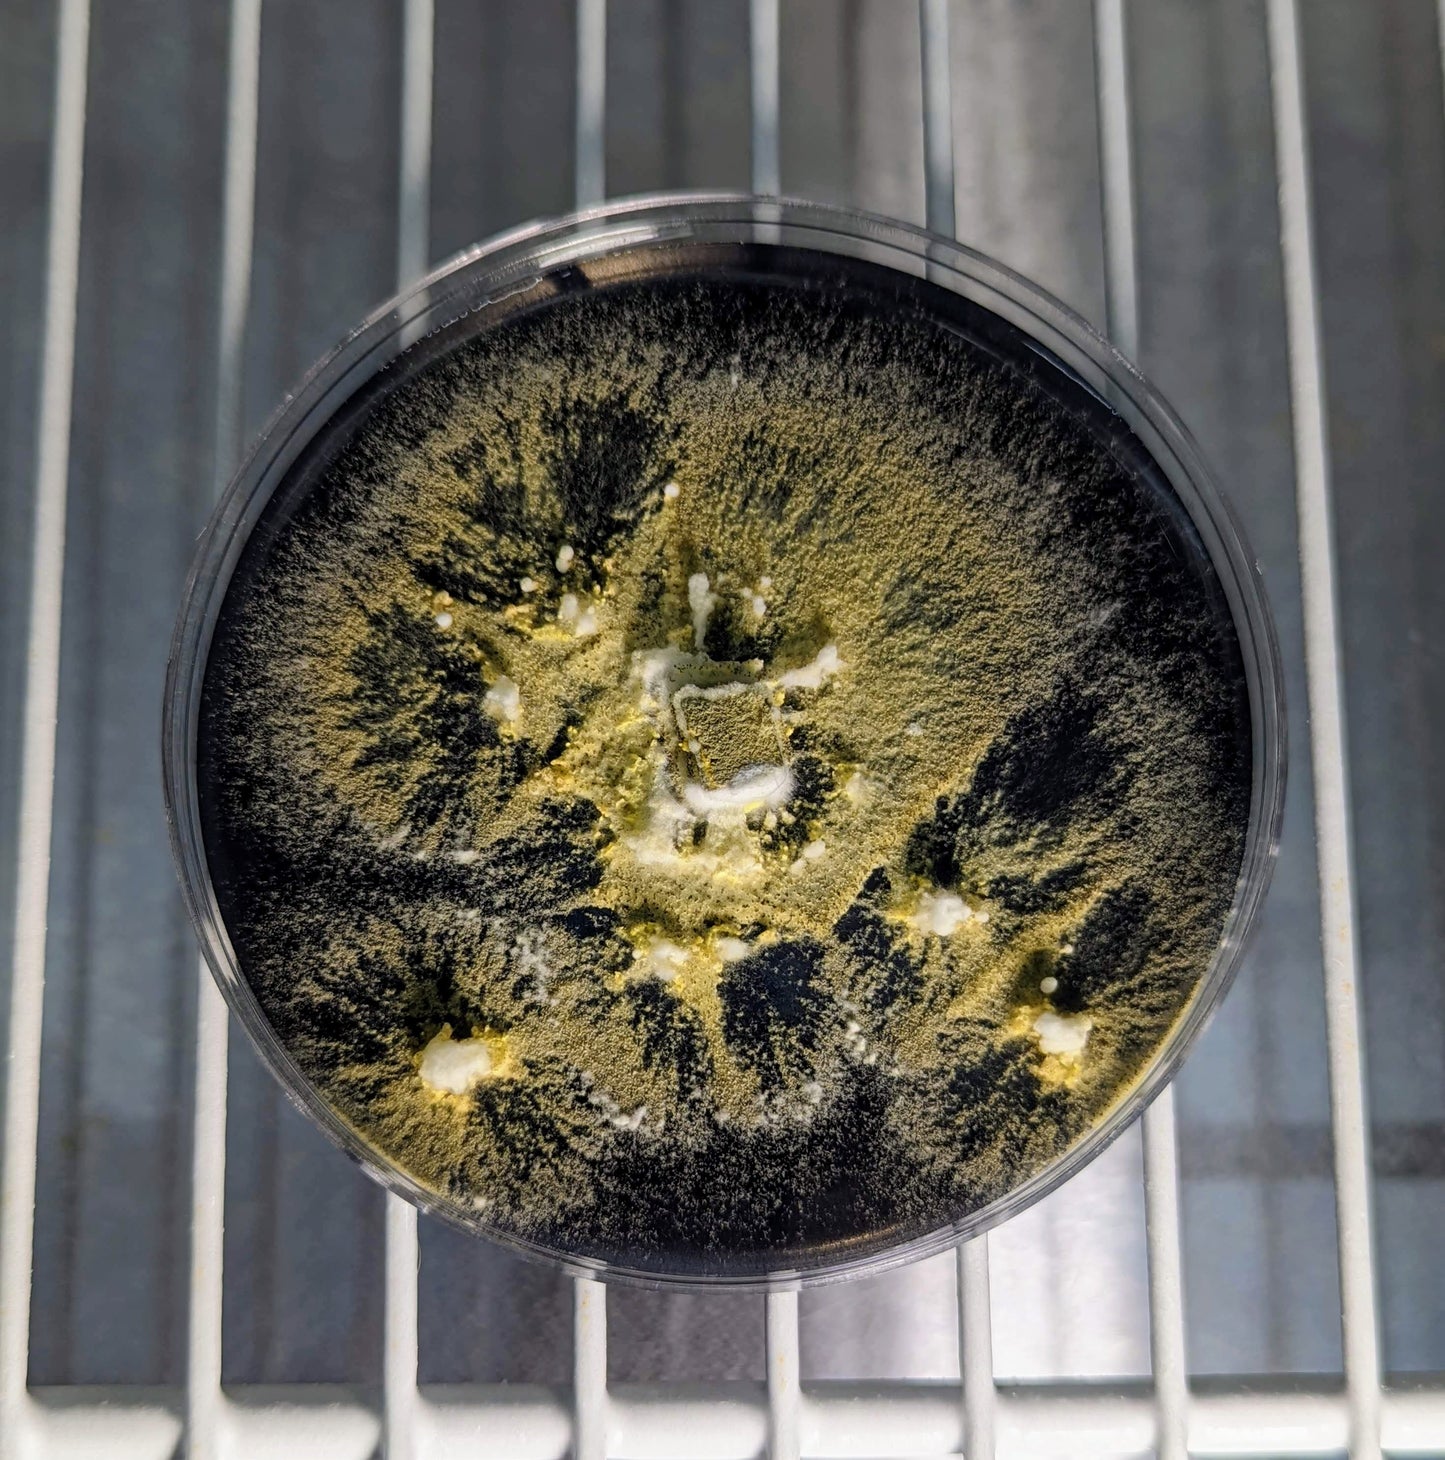

Prime Fungi
Metarhizium anisopliae
Metarhizium anisopliae
Couldn't load pickup availability
Metarhizium anisopliae
10 cc/ml liquid fungi mycology culture syringe with a sterile needle.
Metarhizium anisopliae Liquid Culture, natural insect-killing fungus for biological pest control soil treatment and integrated organic farming systems
Metarhizium anisopliae is a soil-dwelling entomopathogenic fungus widely used in biological pest control. It targets a wide variety of insect pests including termites, ants, beetles, thrips, and grasshoppers by infecting and killing them through spore contact. Safe for humans and non-target species, Metarhizium is an effective alternative to chemical pesticides in gardens, greenhouses, and agricultural systems.
This premium liquid culture provides a clean and active strain of Metarhizium anisopliae, ideal for laboratory use, field application, or integration into homemade organic pest control systems.
Key features:
-
Species: Metarhizium anisopliae
-
Type: Liquid fungal culture in sterile nutrient solution
-
Ideal for: Organic pest control, agricultural biocontrol, integrated pest management, greenhouse use, and soil applications
-
Function: Parasitizes and kills insects by penetrating their exoskeleton and proliferating within the host
-
Targets: Termites, ants, beetles, caterpillars, thrips, aphids, whiteflies, grasshoppers, and other soil or leaf-dwelling pests
Why use Metarhizium anisopliae:
-
Powerful natural insecticide that reduces pesticide use
-
Safe for beneficial insects, humans, animals, and plants
-
Compatible with sustainable agriculture and permaculture systems
-
Effective against pesticide-resistant insect populations
-
Suitable for commercial farms, research labs, and home gardens
How to use:
Inoculate sterilized grain or liquid substrate with Metarhizium anisopliae liquid culture. Use to create spore sprays or apply to soil, compost, or crop root zones. Keep moist and apply during moderate humidity conditions for best spore viability and insect exposure.
Metarhizium anisopliae liquid culture is a highly effective tool for growers, researchers, and organic farmers looking for a safe and sustainable solution to manage insect pests naturally.
*international orders will not include needle.
*instructions are not included, please thoroughly research growing conditions and techniques.
Share